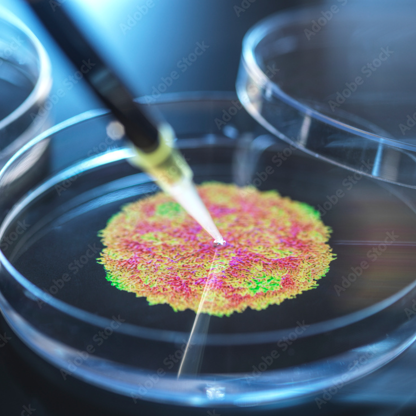

Antimicrobial Stewardship Centers of Excellence Program
The Antimicrobial Stewardship Centers of Excellence program promotes excellence in antimicrobial use and combating antimicrobial resistance by recognizing hospitals that effectively demonstrate excellence in this work.
Possessing a CoE designation signifies a hospital has the policies and processes in place to deliver high-quality stewardship services consistently, execute novel stewardship principles and demonstrate a high-level commitment to improving antimicrobial use and reducing resistance.
Contact
The importance of antimicrobial stewardship
Each year, more than 700,000 people die due to antimicrobial-resistant infections.
- IDSA has promoted antimicrobial stewardship as an avenue to combat AMR for many years. A total of 194 hospitals have received the designation since the program’s launch in 2017, including hospitals in the United Arab Emirates and in India.
- CDC and The Joint Commission have set standards for hospitals to have antimicrobial stewardship programs in place.
- IDSA values recognizing those institutions with comprehensive ASPs, which can further guide other hospitals.
View Full List of Designated Hospitals
The IDSA Antimicrobial Stewardship Center of Excellence designation offers numerous advantages for programs. Among these benefits are enhanced recognition for stewardship efforts, access to a supportive network of other IDSA Centers of Excellence and the ability to uphold the standards required for regulatory compliance, as outlined in our resource guide.
Programs aspiring to obtain this designation and those seeking renewal can utilize this guide to secure backing from hospital leadership.
The Centers of Excellence designation program aligns with evidence-based national guidelines such as the IDSA-SHEA guidelines and CDC’s Core Elements of Hospital Antibiotic Stewardship Programs.
View Full List of Designated Hospitals
How to apply for a Center of Excellence designation
Applications from individual hospitals are accepted twice per year and must be submitted by an active IDSA member. Designation is for two years and includes a license fee of $5000 per hospital.